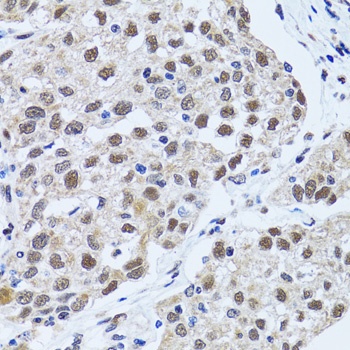
产品细节图片3

相关产品推荐更多 >
万千商家帮你免费找货
0 人在求购买到急需产品
- 详细信息
- 文献和实验
- 技术资料
- 抗体名:
53BP1 Antibody抗体
- 抗体英文名:
53BP1 Antibody
- 靶点:
TP53BP1
- 浓度:
batch dependent
- 应用范围:
IF, IHC, WB
- 适应物种:
Human, Mouse, Rat
- 保质期:
6-12个月
- 抗原来源:
详询
- 目录编号:
orb1257346
- 级别:
科研级
- 库存:
88
- 供应商:
biorbyt
- 标记物:
Unconjugated
- 克隆性:
Polyclonal
- 形态:
Liquid
- 亚型:
IgG
- 免疫原:
Recombinant fusion protein containing a sequence corresponding to amino acids 1763-1977 of human 53BP1 (NP_001135452.1).
- 规格:
100 ul
别名:TP53BP1, 53BP1, p202, p53-binding protein 1, p53-binding protein 53bp1, p53BP1
免疫原:Recombinant fusion protein containing a sequence corresponding to amino acids 1763-1977 of human 53BP1 (NP_001135452.1).
分子量:Observed: 255kDa
应用注释:WB: 1:500 - 1:2000IHC: 1:50 - 1:200IF: 1:50 - 1:200
防腐剂:Liquid
纯化:Affinity 纯化
保存说明:Maintain refrigerated at 2-8°C for up to 2 weeks. For long term storage store at -20°C in small aliquots to prevent freeze-thaw cycles.
UniProt ID:Q12888
Note:For research use only.

风险提示:丁香通仅作为第三方平台,为商家信息发布提供平台空间。用户咨询产品时请注意保护个人信息及财产安全,合理判断,谨慎选购商品,商家和用户对交易行为负责。对于医疗器械类产品,请先查证核实企业经营资质和医疗器械产品注册证情况。
 文献和实验
文献和实验Probing the Telomere Damage Response
to the activation of DNA damage checkpoint sensors, including the Mre11-Rad50-Nbs1 (MRN) complex, γ-H2AX and 53BP1, the ATM and ATR signal-transducing kinases and downstream effectors, including Chk1, Chk2, and p53. Robust DNA damage response signals
作用强度是否发生变化,通过免疫荧光实验检测这些蛋白在细胞内的亚显微定位有何变化。比如ATM,ATR,Chk1,Chk2,MDC1,53BP1,MRN complex,p53,p21,cdc25等,其实有很多蛋白都与DNA损伤介导的细胞周期阻滞有关,多查一些文献,再确定具体的研究方向。 本文由丁香园论坛提供,想了解更多有用的、有意思的前沿资讯以及酷炫的实验方法的你,都可以成为师兄的好伙伴 师兄微信号:shixiongcoming
of interactions are shown; sequence-specific DNA binding through the core region (1TUP.pdb, Gorina et al. Science vol. 265, 346), binding with 53BP1 BRCT domains (1GZH.pdb, Derbyshire et al. EMBOJ vol. 21, 3863) and a tetramer of the c-terminal oligomerization
 技术资料
技术资料暂无技术资料 索取技术资料










